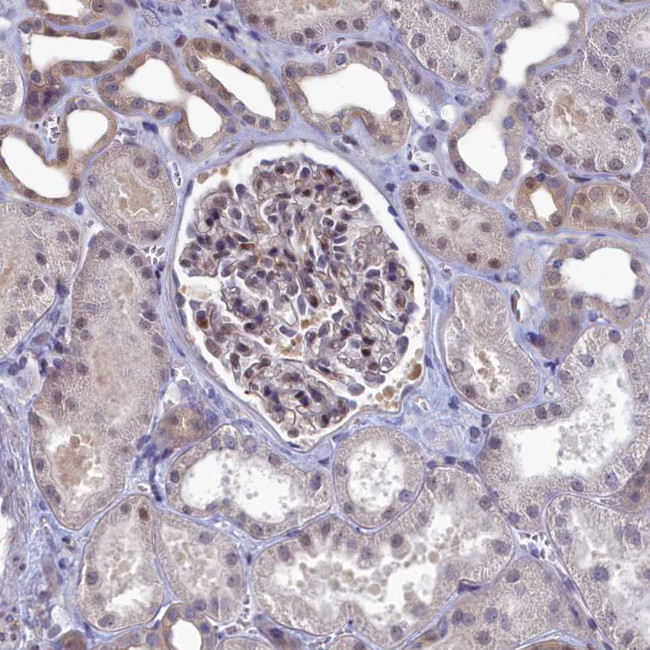
Ubiquitin C Antibody in Immunohistochemistry (Paraffin) (IHC (P))

Search
Invitrogen
Ubiquitin C Polyclonal Antibody
{{$productOrderCtrl.translations['antibody.pdp.commerceCard.promotion.promotions']}}
{{$productOrderCtrl.translations['antibody.pdp.commerceCard.promotion.viewpromo']}}
{{$productOrderCtrl.translations['antibody.pdp.commerceCard.promotion.promocode']}}: {{promo.promoCode}} {{promo.promoTitle}} {{promo.promoDescription}}. {{$productOrderCtrl.translations['antibody.pdp.commerceCard.promotion.learnmore']}}




Please note: We are reviewing Western blot images included in the antibody testing data in our catalog, including those provided by third parties. Unless expressly labeled or annotated as “raw-unedited”, Western blot images included in the antibody testing data in our catalog may have been edited, optimized or otherwise adjusted for presentation.
产品信息
PA5-83550
种属反应
宿主/亚型
分类
类型
抗原
偶联物
形式
浓度
规格
纯化类型
保存液
内含物
保存条件
运输条件
RRID
产品详细信息
Immunogen sequence: MQIFVKTLTG KTITLEVEPS DTIENVKAKI QDKEGIPPDQ Q
Highest antigen sequence indentity to the following orthologs: Rat - 100%, Mouse - 100%.
靶标信息
This gene encodes ubiquitin, one of the most conserved proteins known. Ubiquitin is required for ATP-dependent, nonlysosomal intracellular protein degradation of abnormal proteins and normal proteins with a rapid turnover. Ubiquitin is covalently bound to proteins to be degraded, and presumably labels these proteins for degradation. Ubiquitin also binds to histone H2A in actively transcribed regions but does not cause histone H2A degradation, suggesting that ubiquitin is also involved in regulation of gene expression. This gene consists of three direct repeats of the ubiquitin coding sequence with no spacer sequence. Consequently, the protein is expressed as a polyubiquitin precursor with a final amino acid after the last repeat. Aberrant form of this protein has been noticed in patients with Alzheimer's and Down syndrome.
仅用于科研。不用于诊断过程。未经明确授权不得转售。